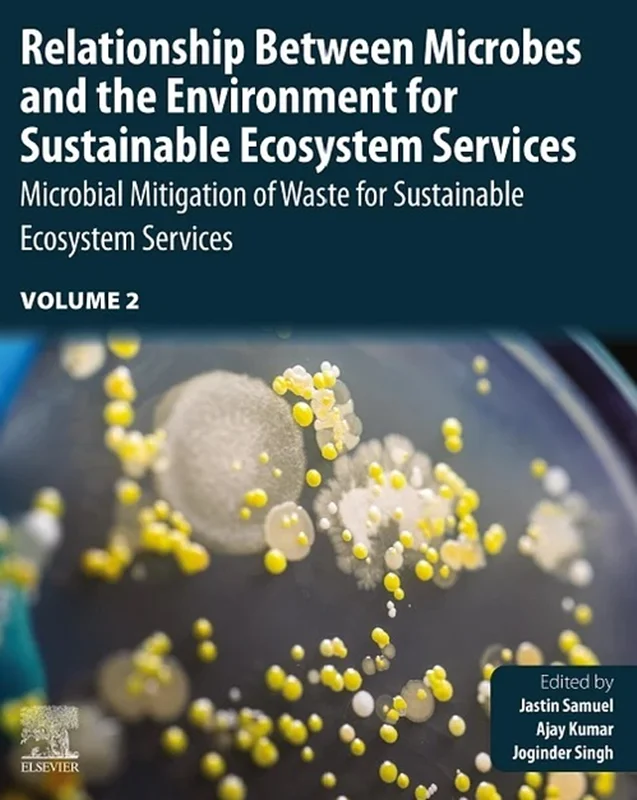

Relationship Between Microbes and the Environment for Sustainable Ecosystem Services, Volume 2: Microbial Mitigation of Waste for Sustainable Ecosystem Services
Jastin Samuel, Ajay Kumar, Joginder Singh Panwar, B0BBLVY6QV, 0323899374, 9780323899376, 978-0-323-89937-6, 978-0323899376
English | 2022 | PDF | 15 MB | 352 Pages
Relationship Between Microbes and Environment for Sustainable Ecosystem Services, Volume Two: Microbial Mitigation of Waste for Sustainable Ecosystem Services promotes advances in sustainable solutions, value-added products, and fundamental research in microbes and the environment. Topics include advanced and recent discoveries in the use of microbes for sustainable development. Volume Two describes the successful application of microbes and their derivatives for waste management of potentially toxic and relatively novel compounds. This proposed book will be helpful to environmental scientists, experts and policymakers working in the field of microbe- based mitigation of environmental wastes.
The book provides reference information ranging from the description of various microbial applications for the sustainability in different aspects of food, energy, environment industry and social development.
- Covers the latest developments, recent applications and future research avenues in microbial biotechnology for sustainable development
- Includes expressive tables and figures with concise information about sustainable ecosystem services
- Provides a wide variety of applications and modern practices of harnessing the potential of microbes in the environment